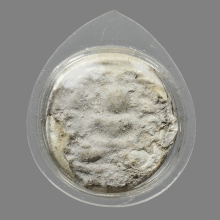
พระผง พิมพ์จันทร์ลอย กรุวัดคู้สลอด

พระเด่นประจำร้านค้า
เหรียญสังฆาฏิ ท่านเจ้าคุณนรฯ วัดเทพศิรินทร์ฯ บล็อก ต สั้น
| 27.01.2569 | 187 |
เหรียญนาคปรกจเร ท่านเจ้าคุณนรฯ วัดเทพศิรินทร์ฯ บล็อก 3 จุด
| 27.01.2569 | 210 |
พระผงวิเศษ 9 พรรษา หลวงปู่นาค วัดระฆังฯ ปี 2495
| 11.01.2569 | 246 |
พระสมเด็จ พิมพ์เทวดาอกร่อง หลวงปู่นาค วัดระฆังฯ ปี 2495
| 09.01.2569 | 316 |
พระนางพญา หลวงปู่นาค วัดระฆังฯ ปี 2495
| 08.01.2569 | 282 |
รายการอัพเดทล่าสุด
พระสมเด็จ พิมพ์แขนกว้าง วัดปราสาทฯ ปี 2506
| 03.03.2569 | 26 |
พระสมเด็จ พิมพ์คะแนน พระครูมูล วัดสุทัศน์ฯ ปี 2495
| 03.03.2569 | 22 |
พระสมเด็จ พิมพ์สามเหลี่ยม พระครูมูล วัดสุทัศน์ฯ ปี 2495
| 03.03.2569 | 13 |
พระสมเด็จ พิมพ์เทวดาอกร่อง หลวงปู่นาค วัดระฆังฯ ปี 2485
| 26.02.2569 | 74 |
พระสมเด็จ พิมพ์พระครูมูล วัดประสาทบุญญาวาส ปี2506
| 26.02.2569 | 31 |
พระผงของขวัญ วัดเกาะจันทร์ พิมพ์กลาง
| 14.02.2569 | 139 |
พระรอด วัดพระสิงห์ เนื้อดิน จ.เชียงใหม่
| 14.02.2569 | 129 |
พระปิดตาหลังฉัตร หลวงปู่เฮี้ยง วัดป่า จ.ชลบุรี
| 12.02.2569 | 75 |
พระผงวัดปากน้ำ รุ่น4 พิมพ์สี่เหลี่ยม หน้านาง
| 12.02.2569 | 140 |
พระผงวัดปากน้ำ รุ่น4 พิมพ์สี่เหลี่ยม หน้าแก่
| 12.02.2569 | 142 |
พระกริ่งอรหัง หลวงพ่อโอภาสี ปี 2498
| 09.02.2569 | 77 |
พระชัยวัฒน์จอมทอง เจ้าคุณผล วัดหนัง
| 09.02.2569 | 60 |
พระผงปากน้ำ รุ่น4 พระธรรมขันธ์ พิมพ์สามเหลี่ยม
| 09.02.2569 | 57 |
พระผง พิมพ์จันทร์ลอย กรุวัดคู้สลอด
| 06.02.2569 | 58 |
เหรียญหลวงปู่บุญ วัดกลางบางแก้ว ปี 2519
| 06.02.2569 | 40 |
เหรียญหลวงปู่เอี่ยม วัดหนัง ออกวัดโคนอน ปี 2514
| 06.02.2569 | 40 |
พระสมเด็จผาสุก เจ้าคุณนรฯ วัดเทพศิรินทร์
| 05.02.2569 | 109 |
พระผงวัดปากน้ำ รุ่น 4 จ.กรุงเทพฯ
| 05.02.2569 | 117 |
เหรียญหลวงพ่อโอภาสี ปี 2497
| 03.02.2569 | 86 |
พระผงของขวัญ วัดปากน้ำ รุ่น 6
| 03.02.2569 | 127 |
พระขรัวอีโต้ กรุวัดเลียบ จ.กรุงเทพฯ
| 03.02.2569 | 87 |
พระขรัวอีโต้ กรุวัดเลียบ จ.กรุงเทพ (พระรอดเมืองใต้)
| 28.01.2569 | 252 |
พระสมเด็จ พิมพ์คะแนนลึก หลวงตาพัน
| 28.01.2569 | 188 |
เหรียญถวายภัตตาหาร หลวงพ่อสด วัดปากน้ำ รุ่น2
| 26.01.2569 | 109 |
เหรียญกันภัย หลวงพ่อสด วัดปากน้ำ ภาษีเจริญ ปี 2509
| 26.01.2569 | 71 |
พระจันทร์ลอย วัดประสาทบุญญาวาส ปี2506 พิมพ์ใหญ่
| 24.01.2569 | 109 |
พระจันทร์ลอย วัดประสาทบุญญาวาส ปี2506 พิมพ์เล็ก
| 24.01.2569 | 125 |
พระกลีบบัว วัดลิงขบ(วัดบวรมงคล) จ.กรุงเทพฯ
| 23.01.2569 | 108 |
เหรียญหลวงพ่อเพิ่ม วัดกลางบางแก้ว ปี 2522
| 23.01.2569 | 54 |
พระพิจิตรข้างเม็ด กรุวัดเขาพนมเพลิง จังหวัดสุโขทัย
| 23.01.2569 | 137 |
พระสมเด็จ พิมพ์เกศบัวตูม พระครูมูล วัดสุทัศน์ฯ ปี 2485
| 21.01.2569 | 216 |
พระสมเด็จ พิมพ์มีหน้ามีตา พระครูมูล วัดสุทัศน์ฯ ปี 2495
| 21.01.2569 | 165 |
พระสมเด็จ วัดปราสาทฯ ปี 2506 พิมพ์คะแนนจิ๋ว
| 21.01.2569 | 166 |
พระปิดตา หลวงปู่บุญ วัดกลางบางแก้ว จ.นครปฐม
| 20.01.2569 | 100 |
พระปรกตัวหนอน ฐานสามชั้น (นิยม) เนื้อดิน
| 20.01.2569 | 150 |
พระหลวงปู่ชู วัดนาคปรก พิมพ์หลวงพ่อโต เนื้อดิน
| 20.01.2569 | 140 |
พระบูชารัตนะ หน้าตัก 1.8นิ้ว
| 18.01.2569 | 79 |
รูปหล่อไต้ฮงกง รุ่น 2 ปี 2513 หัวกลึง(นิยม)
| 17.01.2569 | 65 |
พระกรุวัดสามปลื้ม พิมพ์สามเหลี่ยมใหญ่ จ.กรุงเทพฯ
| 13.01.2569 | 177 |
พระโคนสม พิมพ์มารวิชัยจ.พระนครศรีอยุธยา
| 09.01.2569 | 135 |
รูปหล่อไต้ฮงกง รุ่น 2 ปี 2513 หัวกลึง
| 07.01.2569 | 108 |
พระกรุวัดเงินคลองเตย จ.กรุงเทพฯ พิมพ์เล็บมือ
| 06.01.2569 | 202 |
พระจันทร์ลอย วัดประสาทบุญญาวาส ปี2506
| 06.01.2569 | 188 |
พระบูชารัตนะ หน้าตัก 1.5นิ้ว
| 03.01.2569 | 121 |